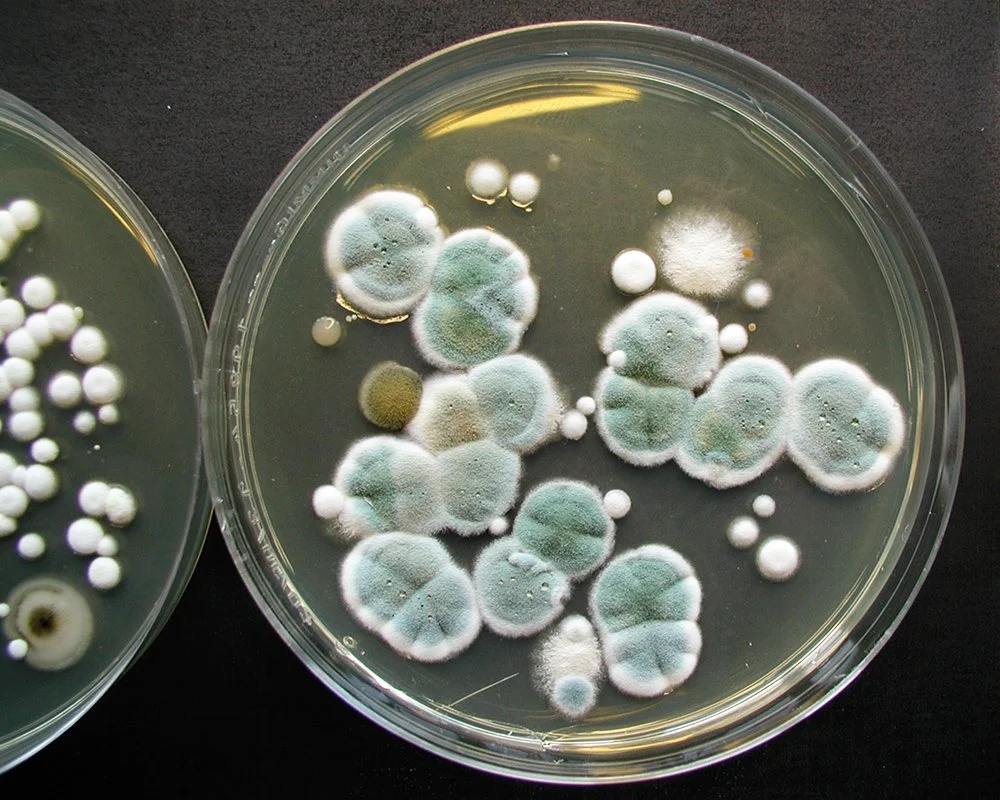

Inneklima
CYTOX har lang erfaring i å håndtere fukt, soppskader og andre problemstillinger i forhold til begrepet inneklima.

Med begrepet “inneklima” menes det klimaet vi oppholder oss i når vi er innendørs. Begrepet omfatter mange såkalte “inneklimafaktorer”, der det de siste ti-årene har vært fokusert mye på inneklimafaktorene fukt- og muggsopp. Årsaken til dette er mange, men utette bygg og mangler ved utført håndverk topper listen av skadeårsaker.
Fuktskader kan gi konstruktive skader i en bygning, samt mange mer eller mindre plagsomme helseeffekter for den som oppholder seg der. Det er derfor viktig å holde tak og fasader i god stand, slik at nedbør ikke får komme inn i bygningen og skade denne på noen måte.
Det er også viktig at alt byggearbeid utføres iht. god bygge- og håndverkskikk slik at man unngår kondensvann som følge av det motsatte. Et normalt godt luftskifte er også viktig for opplevelsen av et godt inneklima.

Cytox AS utfører mange typer inneklima undersøkelser
Slike undersøkelser kan være;
Luftmålinger og kartlegging av CO 2-nivåer (spesielt aktuelt for arbeidsplasser
Radonmålinger, både i privat hjem og for arbeidsplasser
Kartlegging av muggsoppmengder i inneluft
Ventilasjonstekniske undersøkelser
Analyser & rapporter i tilknyting til undersøkelsene
Påvises avvik i forhold til relevante normer, og/eller forskrifter, kan vi bidra med gode råd for nødvendige tiltak. Vi kan også gjennomføre slike tiltak om ønskelig.
Materialanalyser
Vi utfører analyse av materialer der det mistenkes muggsoppvekst og/eller angrep av råtesopp. Materialet kan sendes til oss pr. post eller vi tar det med ved en eventuell befaring. Dersom materialet skal sendes som brevpost må det pakkes i papir og ikke plast da dette kan skade prøven hvis prøvematerialet ikke er helt tørt. Materialet analyseres på laboratoriet hos Cytox, og kunden får svar på hva som er funnet.
Våre fagfolk har lang erfaring i å håndtere fukt, soppskader og andre problemstillinger i forhold til begrepet inneklima.
Kontakt våre fagfolk i dag for mer informasjon, synfaring og inneklimaundersøkelser.
Døgnservice 24/7
•
tlf. 55 99 86 00
•
Døgnservice 24/7
•
tlf. 55 99 86 00
•
Døgnservice 24/7 • tlf. 55 99 86 00 • Døgnservice 24/7 • tlf. 55 99 86 00 •
Inneklima, ofte stilte spørsmål
Jeg har flyttet inn i ny leilighet/hus og føler meg (litt) dårlig. Kan muggsopper være årsak til plagen, og kan dere måle dette?
Ved “måling av muggsopper” bestemmes soppmengder og sopparter av disse i inneluften. Rutinemessig tas det også prver av uteluften, da dette i mange tilfeller kan være av interesse som sammenligningsgrunnlag. Normal gjennomføres også andre fukt- og bygningsmessige undersøkeler parallelt med en “soppmåling”, siden en måling av muggsopper alene normalt ikke er tilstrekkelig for et godt nok inntrykk av et inneklima.
Er muggsopp farlig?
Muggsopper er en naturlig del av klimaet utendørs. Mengdene følger årstidene, hvor vinteren er lavsesong for soppene. De aller fleste av oss er bygget for å tåle de naturlige variasjonene i muggsoppmengder rundt oss. Men etablerer soppene seg innomhus kan dette gi en overeksponering og få følger i form av forskjellige typer plager, i første omgang for sensible personer.
Som det meste av det vi påvirkes av, så er det mengde og eksponeringstid som avgjør om noe er farlig eller ikke. Det er ingen tvil om at enkelte muggsopptyper kan skape vesentlig plage for enkelte, og vi vil alle oppleve plager hvis soppmengdene blir store nok. Det er derfor viktig å unngå sopputvikling innomhus. Skulle man påvise muggsopper, så er det viktig å kontakte noen som kan fortelle hvordan man håndterer både soppene og de forholdene som har skapt sopputviklingen.
Hva koster en soppmåling?
En soppmåling koster fra rundt kr. 7.000,- + mva og oppover. Kostnaden beregnes i grove trekk ut fra medgått tid til undersøkelsen, analyse av innsamlet prøvemateriale, samt en påfølgende rapport om det som er påvist.
Må jeg organisere en skadeutbedring selv, eller er det noe dere kan gjøre?
Vi kan organisere hele skadeutbedringen, der vi skaffer til veie de håndverksfag som måtte være aktuelle utover det vi selv har av kompetanse. En slik løsning sikrer en smidig gjennomføring som vil ha positiv betydning for utbedringskostnaden.
Ønsker dere som oppdragsgiver selv å bidra til deler av arbeidet, så er dette mulig. Vi må da planlegge dette inn i resten av arbeidet. Dette gjelder også om dere ønsker å benytte egeninnleid arbeidskraft.
Er det farlig å bo i huset mens arbeidet pågår?
I utgangspunktet; nei. Det som imidlertid kan gjøre det vanskelig å bo i huset mens arbeidet pågår er støy, bygningsstøv osv, over relativt lengre perioder. De fleste velger da å bo et annet sted mend arbeidet pågår. Bor man i én etasje mens arbeidet pågår i en annen etasje, er det vanligvis gjennomførbart.
Hva koster det å reparere en soppskade?
Utbedringskostnaden bestemmes av skadens omfang. Vi anbefaler en skadebesiktigelse for et så godt som mulig grunnlag for et prisestimat.






